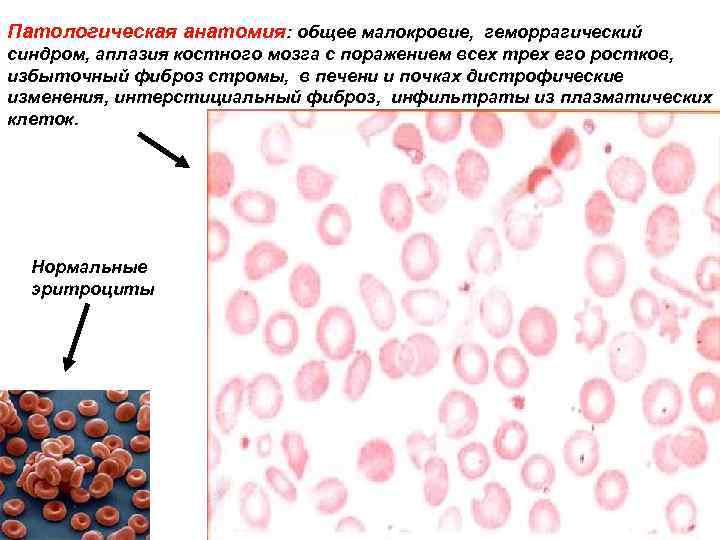
Патологическая анатомия: общее малокровие, геморрагический синдром, аплазия костного мозга с поражением всех трех его

Профессиональные интоксикации с преимущественным поражением системы крови 1 кафедра внутренних болезней БГМУ 2010
Профессиональные интоксикации с преимущественным поражением системы крови 1 кафедра внутренних болезней БГМУ 2010
 Особенности Классификация соответствует основным нозологическим формам 1. Возникновение и развитие патологического процесса определяется характером действующего этиологического фактора 2. Степень выраженности и характер патологического изменения крови зависит от концентрации действующего вещества в воздухе рабочей зоны, путей проникновения в организм, его метаболизма и выделения. 3. Гематологические нарушения сочетаются с клинико-лабораторными признаками поражения других органов и систем: дыхательной, нервной, сердечнососудистой, и др. 4. Патологический процесс имеет тенденцию к восстановлению при своевременном прекращении действия патологического агента
Особенности Классификация соответствует основным нозологическим формам 1. Возникновение и развитие патологического процесса определяется характером действующего этиологического фактора 2. Степень выраженности и характер патологического изменения крови зависит от концентрации действующего вещества в воздухе рабочей зоны, путей проникновения в организм, его метаболизма и выделения. 3. Гематологические нарушения сочетаются с клинико-лабораторными признаками поражения других органов и систем: дыхательной, нервной, сердечнососудистой, и др. 4. Патологический процесс имеет тенденцию к восстановлению при своевременном прекращении действия патологического агента
 Особенности диагностики • Периферические параметры крови сравнивают с нормой • Периферическая кровь в динамике • Анализ анамнестических данных • Специфические методы диагностики • Тест «элиминации» (улучшение после прекращения контакта с вредным фактором) • «Реэкспозиции» (ухудшение после возобновления контакта).
Особенности диагностики • Периферические параметры крови сравнивают с нормой • Периферическая кровь в динамике • Анализ анамнестических данных • Специфические методы диагностики • Тест «элиминации» (улучшение после прекращения контакта с вредным фактором) • «Реэкспозиции» (ухудшение после возобновления контакта).
 Классификация • Депрессии кроветворения • Заболевания, обусловленные нарушением синтеза порфиринов и гема • Изменения пигмента крови • Гемолитическая анемия
Классификация • Депрессии кроветворения • Заболевания, обусловленные нарушением синтеза порфиринов и гема • Изменения пигмента крови • Гемолитическая анемия
 Амино и нитро производные бензола – ПДК 5 мгм куб Оксид углерода Цианиды Депрессии гемопоэза Патогенез • Непосредственное токсическое действие на полипотентные стволовые клетки • Токсическое действие на неклеточные элементы стромы костного мозга • Следствием является сужение плацдарма кроветворения • Опосредованное воздействие гемодепрессоров, обусловленное вмешательством в перекисное окисление липидов, синтез ДНК окислительное фосфорилирование • Участие аутоиммунных процессов в развитии гемодепрессии
Амино и нитро производные бензола – ПДК 5 мгм куб Оксид углерода Цианиды Депрессии гемопоэза Патогенез • Непосредственное токсическое действие на полипотентные стволовые клетки • Токсическое действие на неклеточные элементы стромы костного мозга • Следствием является сужение плацдарма кроветворения • Опосредованное воздействие гемодепрессоров, обусловленное вмешательством в перекисное окисление липидов, синтез ДНК окислительное фосфорилирование • Участие аутоиммунных процессов в развитии гемодепрессии
Патологическая анатомия: общее малокровие, геморрагический синдром, аплазия костного мозга с поражением всех трех его ростков, избыточный фиброз стромы, в печени и почках дистрофические изменения, интерстициальный фиброз, инфильтраты из плазматических клеток. Нормальные эритроциты
Патологическая анатомия: общее малокровие, геморрагический синдром, аплазия костного мозга с поражением всех трех его ростков, избыточный фиброз стромы, в печени и почках дистрофические изменения, интерстициальный фиброз, инфильтраты из плазматических клеток. Нормальные эритроциты
 Депрессии гемопоэза Патологическая анатомия
Депрессии гемопоэза Патологическая анатомия
 Клиника Стойкие Транзиторные Анемический синдром: общая слабость, утомляемость, головокружения, головная боль, одышка при физической нагрузке Тромбоцитопенический синдром: кровоточивость десен, кожные геморрагии, носовые кровотечения, меноррагии. Лейкопенический синдром: Диагностическое значение имеет стойкое снижение лейкоцитов менее 4*109л.
Клиника Стойкие Транзиторные Анемический синдром: общая слабость, утомляемость, головокружения, головная боль, одышка при физической нагрузке Тромбоцитопенический синдром: кровоточивость десен, кожные геморрагии, носовые кровотечения, меноррагии. Лейкопенический синдром: Диагностическое значение имеет стойкое снижение лейкоцитов менее 4*109л.
 Заключение • Профессиональный контакт с кровяными ядами возможен во многих отраслях промышленности • В зависимости от основного повреждающего механизма выделяют следующие клинические группы интоксикаций кровяными ядами: депрессии гемопоэза, нарушение синтеза гемоглобина и гемолитические анемии. • Тяжесть клинических проявлений зависит, как правило, от концентрации и интенсивности воздействия патогена
Заключение • Профессиональный контакт с кровяными ядами возможен во многих отраслях промышленности • В зависимости от основного повреждающего механизма выделяют следующие клинические группы интоксикаций кровяными ядами: депрессии гемопоэза, нарушение синтеза гемоглобина и гемолитические анемии. • Тяжесть клинических проявлений зависит, как правило, от концентрации и интенсивности воздействия патогена
 Заключение • Диагностика острых форм, как правило, не вызывает затруднений. • При тяжелых формах интоксикаций наблюдается полиорганность поражений, возможны летальные исходы, в отдаленном периоде характерны остаточные явления и частичная или полная утрата трудоспособности. • Ведущее значение в предотвращении социально-экономических потерь в связи с профессиональными интоксикациями кровяными ядами, впрочем как и другими, принадлежит первичной профилактике.
Заключение • Диагностика острых форм, как правило, не вызывает затруднений. • При тяжелых формах интоксикаций наблюдается полиорганность поражений, возможны летальные исходы, в отдаленном периоде характерны остаточные явления и частичная или полная утрата трудоспособности. • Ведущее значение в предотвращении социально-экономических потерь в связи с профессиональными интоксикациями кровяными ядами, впрочем как и другими, принадлежит первичной профилактике.